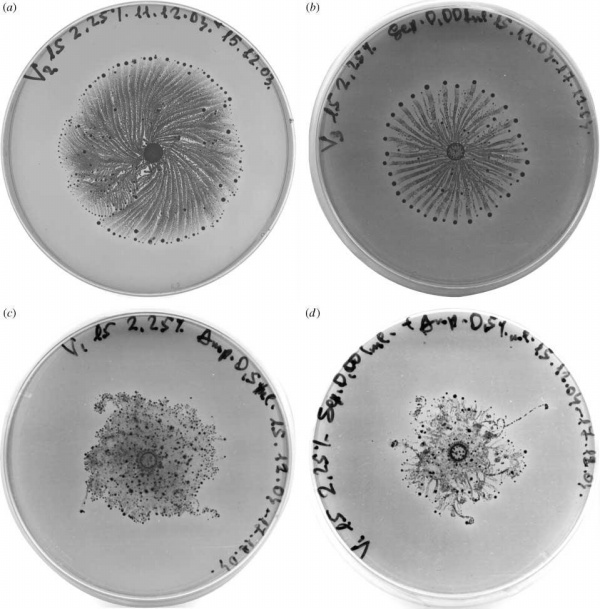
/gkimage/ms/ux/bc/msuxbc.png

来,先猜猜看,这是什么?6 u) u [+ Y! P6 H: n+ ^
/gkimage/v7/hw/yh/v7hwyh.png
 这又是什么?
这又是什么?
. v" i: y. r1 Q+ J. n% Q. L I
/gkimage/wh/13/4z/wh134z.png
 如果觉得以上图案的梦幻程度实在有超出你的想象,不大好确认的话。那么来看看这两只吧——
如果觉得以上图案的梦幻程度实在有超出你的想象,不大好确认的话。那么来看看这两只吧——
( `* I, d$ s; ~2 O' u! N
/gkimage/to/1d/w0/to1dw0.png
 此时一定有人已经脱口而出了:哦,细菌培养皿啊!
此时一定有人已经脱口而出了:哦,细菌培养皿啊!
0 S' r+ Q C! a: L8 ]8 {- q, g( @答对了,加十分!前两幅漂亮得不可思议的画,那的确是细菌画的。
/ i6 R8 {7 R' v3 W4 G% S" o搜集了这些“画儿”的人,名叫Herbert Levine,是来自美国加州大学圣迭戈分校的一位生物学家,做的细菌研究,工作重点在于搞清楚细菌耐药性的根源。所以你可以想象,他们家实验室里养满了诸如金黄葡萄球菌超级细菌这样一类东东。每天,HL老师带领着自己的团队,喂养不辍,就为了从一些基础的生物过程中,找到细菌们争取资源和空间的秘密法宝。一般来说,他们是通过控制温度和食物源(营养源)来调整其生长模式,这样便能初步观察到这些生物的生存谋略。9 L0 |) D) e! E2 l$ W7 ]5 X
但HL老师显然不甘于那么不浪漫的本职,人家可是一位有着文艺细胞的科学家——所以长了个心眼,悄悄地把实验做得非常好看,最后竟变成艺术品来和大家一起欣赏。老师后来在论文里介绍到,他发现细菌有一种自构建能力,能在各种环境下长出不同分布模式,只要加以适当的表现就可形成为视觉上可感的图像。就像下图,被他称作典型的枝状模式,由一种 P. dendritiformis 细菌在贫营养的条件下生成。
) r' U5 w; u' R" U3 I5 U
/gkimage/bm/q0/b4/bmq0b4.png
 一般来说,实验室里养菌需要用到一种LB液体培养基,里面包括蛋白胨、氯化钠等成分,辅以适量琼脂以供菌们消耗。但上面a图中这个培养皿,蛋白胨浓度大大低于标准的10克/升,仅有2克/升,琼脂浓度也只有可怜的2%,实在有饿死它们的嫌疑。实验开始时,研究人员先让培养液在温度为25℃、湿度为50%的环境下干燥,随后把一滴大约含有1万个细菌的液滴滴入培养皿,让它们长了两天,扩散出直径为5厘米的一个区域,接着就置于显微镜下观察。前三幅都是通过偏光显微镜看到的,a图为整个概貌,b图为细菌生长中产生的一种液体,c图是放大500倍的局部,而d图则是电镜下面的细菌样子。看到这景象,不得不赞叹它们可真是没有条件创造条件也要长的呢!- ^+ D3 R. K: a5 I- x
一般来说,实验室里养菌需要用到一种LB液体培养基,里面包括蛋白胨、氯化钠等成分,辅以适量琼脂以供菌们消耗。但上面a图中这个培养皿,蛋白胨浓度大大低于标准的10克/升,仅有2克/升,琼脂浓度也只有可怜的2%,实在有饿死它们的嫌疑。实验开始时,研究人员先让培养液在温度为25℃、湿度为50%的环境下干燥,随后把一滴大约含有1万个细菌的液滴滴入培养皿,让它们长了两天,扩散出直径为5厘米的一个区域,接着就置于显微镜下观察。前三幅都是通过偏光显微镜看到的,a图为整个概貌,b图为细菌生长中产生的一种液体,c图是放大500倍的局部,而d图则是电镜下面的细菌样子。看到这景象,不得不赞叹它们可真是没有条件创造条件也要长的呢!- ^+ D3 R. K: a5 I- x
下面是一组不同生长条件下另一种 Paenibacillus 菌长出来的效果。a的条件是蛋白胨浓度7.5克/升,琼脂2.25%;b的条件是蛋白胨浓度20克/升,琼脂2.0%;c的条件是蛋白胨浓度15克/升,琼脂2.25%;d的条件是蛋白胨浓度20克/升,琼脂2.25%。显然,模式还渐趋复杂来着。6 W% E9 M$ t7 u8 Z m/ G
/gkimage/uh/yn/p2/uhynp2.png
 接下来的这个画面显示菌们自行发生了形态转变,从枝状模式转向了手性模式,原因竟然是遇到了研究人员放入的真菌(图b中亮点)。
接下来的这个画面显示菌们自行发生了形态转变,从枝状模式转向了手性模式,原因竟然是遇到了研究人员放入的真菌(图b中亮点)。
0 J, u5 x: N5 T: d
/gkimage/ks/r9/gj/ksr9gj.png
 下面这个是卷曲枝状模式,细菌们越过障碍物(细胞)生长而获得的图案。
下面这个是卷曲枝状模式,细菌们越过障碍物(细胞)生长而获得的图案。
s4 B5 s% X. @- B; z- ^* r
/gkimage/8f/3l/7u/8f3l7u.png
 还有一种不同于以上几种的涡状模式——! M! n+ p \1 P2 r2 o, _/ R
还有一种不同于以上几种的涡状模式——! M! n+ p \1 P2 r2 o, _/ R
/gkimage/n6/fd/z1/n6fdz1.png
 最令人赞叹的一点是菌们十分机灵,能够将自己掩藏在抗生素鞭长莫及之处,以下图案可充分说明这一点,b加入了抗生素磺胺类药物,c加入了抗生素氨苄青霉素,d中则两种都加了,毫无疑问,它们仍然在生长!在对抗过程中,细菌之间也产生了更强的合作。9 y% M0 K8 Y* y" z! N
最令人赞叹的一点是菌们十分机灵,能够将自己掩藏在抗生素鞭长莫及之处,以下图案可充分说明这一点,b加入了抗生素磺胺类药物,c加入了抗生素氨苄青霉素,d中则两种都加了,毫无疑问,它们仍然在生长!在对抗过程中,细菌之间也产生了更强的合作。9 y% M0 K8 Y* y" z! N
/gkimage/ms/ux/bc/msuxbc.png
当然,HL老师实际当做的要比做点儿观察复杂许多,还涉及到了以数学建模的方式去预测细菌模式等工作。下图中,左边是一组实际生长得到的图案,右边是计算机模拟的结果(此处颜色根据细菌密度而设置,不同的颜色正好显示了不同的生长阶段),可以看到,两者很接近。( L o: ] s( g, I0 _# z% ?* P
当然,HL老师实际当做的要比做点儿观察复杂许多,还涉及到了以数学建模的方式去预测细菌模式等工作。下图中,左边是一组实际生长得到的图案,右边是计算机模拟的结果(此处颜色根据细菌密度而设置,不同的颜色正好显示了不同的生长阶段),可以看到,两者很接近。( L o: ] s( g, I0 _# z% ?* P
/gkimage/04/8r/lf/048rlf.png
 了解更多科学家个人主页3 x1 A: ^* C1 ^* F. I. j
了解更多科学家个人主页3 x1 A: ^* C1 ^* F. I. j
细菌作为艺术(带视频)南通0 |  苏公网安备 32060202000307号 © 2001-2019 0513.org All Right Reserved.
苏公网安备 32060202000307号 © 2001-2019 0513.org All Right Reserved.